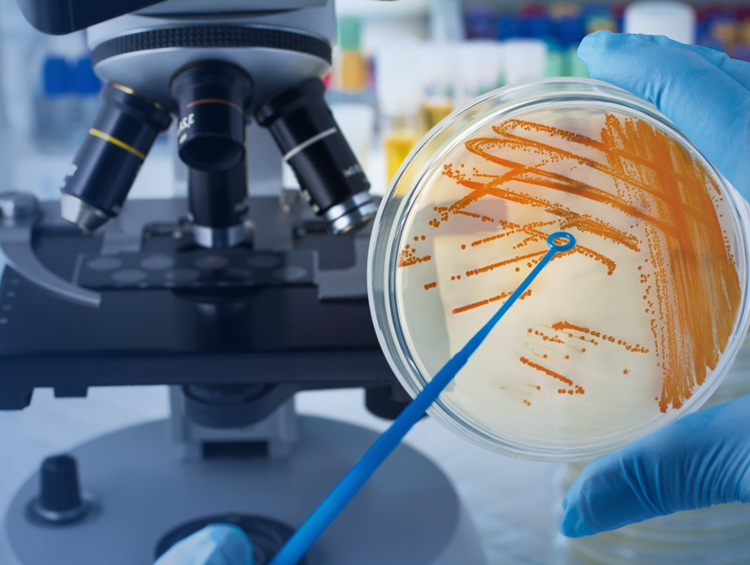

The name itself suggests TRUST, familiarly heard from the slogans of Lord Saibaba as Shraddha and Saburi.
- +91 98251 37055
- spl.maninagar@gmail.com
- Open 24x7 Hours

Microbiology is the study of infectious diseases. From a variety of samples such as urine, faces, swabs, serum and other body fluids, microbiology attempts to grow bacteria in special media, or viruses in cell cultures, in addition to tests such as microscopy and special tests on serum to identify which type of bacteria, fungi, viruses or parasites are causing an infection.
It is important that microbiology areas are as clean as possible and isolated from other areas of the laboratory in order to avoid contamination of samples from the ubiquitous (usually harmless) “germs” that are present all around us. This ensures that only the germs that are causing the infection are present and identified in the test sample. For this reason, a number of areas and rooms in microbiology department are required to be separate from the rest of the laboratory.
Samples can be taken from: